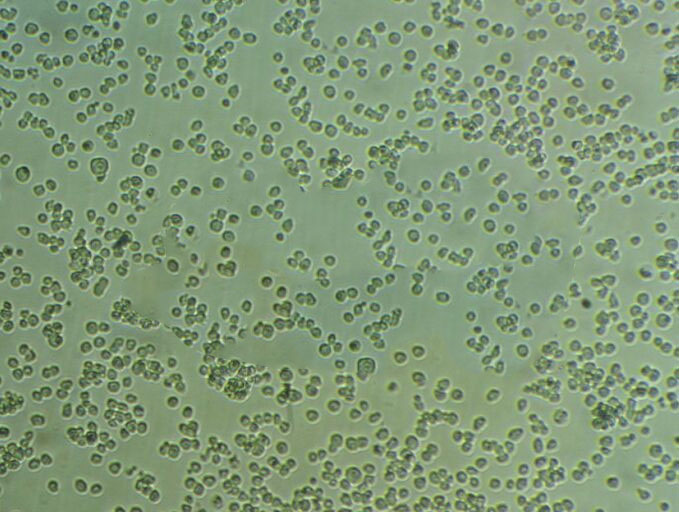
SW48 Cells#人结肠腺癌细胞系实验室|完全培养基|鉴定图谱

"SW48 Cells#人结肠腺癌细胞系实验室|完全培养基|鉴定图谱
换液周期:每周2-3次
传代比例:1:2-1:4(首次传代建议1:2)
背景信息:详见相关文献介绍
在实验室细胞培养过程中,细胞聚集是一个常见的问题,它可能会影响细胞的正常生长、实验结果的准确性等诸多方面。为了防止细胞聚集,科研人员通常会采用多种有效的方法。首先,合适的细胞培养容器表面处理至关重要。许多细胞培养瓶和培养皿会经过特殊的表面处理,例如用亲水性的聚合物涂层。减少细胞之间因为吸附在同一位置而聚集的可能性。酶处理也是常用的手段之一。在细胞消化传代过程中,使用适量的胰蛋白酶等酶试剂。胰蛋白酶能够分解细胞间的连接蛋白,使细胞彼此分离。但是,酶的浓度和处理时间需要严格把控。如果酶浓度过高或者处理时间过长,虽然细胞能够很好地分散,但可能会对细胞造成损伤,影响细胞的活性。以常见的哺乳动物细胞为例,一般使用0.25%的胰蛋白酶,在37℃下处理1-3分钟,就可以有效地将细胞分散开,同时又能保证细胞的健康状态。添加合适的试剂也是防止细胞聚集的有效策略。一些抗聚集剂如乙二胺四乙酸(EDTA)被广泛使用。EDTA能够螯合细胞培养液中的钙、镁离子,而这些离子是细胞间连接所依赖的重要成分。当它们被螯合后,细胞间的连接就会变弱,从而减少聚集。在细胞培养过程中,轻柔的操作也不容忽视。无论是在细胞的接种、换液还是转移过程中,避免剧烈摇晃或吹打。通过这些综合的方法,实验室能够更好地防止细胞聚集,为细胞系培养实验的成功提供保障。
┈订┈购(技术服务)┈热┈线:1┈3┈6┈4┈1┈9┈3┈0┈7┈9┈1【微信同号】┈Q┈Q:3┈1┈8┈0┈8┈0┈7┈3┈2┈4;
AICD58.4 Cells(提供STR鉴定图谱)
LTEP-sm 1 Cells;背景说明:小细胞肺癌;男性;传代方法:1:2-1:3传代;每周换液2-3次。;生长特性:贴壁;形态特性:详见产品说明书;相关产品有:Mono-Mac-6细胞、UPCI-SCC-090细胞、SNU-475细胞
HuH7 Cells;背景说明:详见相关文献介绍;传代方法:消化3-5分钟。1:2。3天内可长满。;生长特性:贴壁生长;形态特性:上皮样;相关产品有:CAL-120细胞、MeT 5A细胞、M 1细胞
SNU1040 Cells;背景说明:结肠癌;男性;传代方法:1:2-1:3传代;每周换液2-3次。;生长特性:贴壁;形态特性:详见产品说明书;相关产品有:16HBE14o-细胞、PLA-801D细胞、RSC 96细胞
生长特性:贴壁生长
SW48 Cells#人结肠腺癌细胞系实验室|完全培养基|鉴定图谱
产品包装:复苏发货:T25培养瓶(一瓶)或冻存发货:1ml冻存管(两支)
来源说明:细胞主要来源ATCC、ECACC、DSMZ、RIKEN等细胞库
如何进行细胞复苏:1)从容器中取出冻存管,直接浸入37℃温水中,并不时摇动令其尽快融化;2)从37℃水浴中取出冻存管,打开盖子,用吸管吸出细胞悬,加到离心管并滴加10倍以上培养,混匀;3)离心,1000rpm,5min;4)弃去上清,加入含10%小牛血清培养重悬细胞,计数,调整细胞密度,接种培养瓶,37℃培养箱静置培养;5)次日更换一次培养,继续培养。【温馨提醒】1)从增殖期到形成致密的单层细胞以前的培养细胞都可以用于冻存,但ZuiHAO为对数生长期细胞。在冻存前一天ZuiHAO换一次培养;2)将冻存管放入容器或从中取出时,要做HAO防护工作(戴棉手套),以免冻伤;3)冻存和复苏ZuiHAO用新配制的培养。细胞复苏的时候,有些初次实验员将冻存管从中取出后,放在室温下,经常发生冻存管爆炸,该怎么避免出现这种情况吗?其中在拧紧冻存管的时候是否有哪些细节要注意的?一般常用的方法是取出冻存管后在超净工作台中用酒精棉球擦试管口,再稍拧松盖子,再放37度水浴锅中摇溶,在将细胞转移到装有37度预热过的培养基的试管中,迅速离心,再用培养基洗一遍。
物种来源:人源、鼠源等其它物种来源
┈订┈购(技术服务)┈热┈线:1┈3┈6┈4┈1┈9┈3┈0┈7┈9┈1【微信同号】┈Q┈Q:3┈1┈8┈0┈8┈0┈7┈3┈2┈4;
Hs604T Cells;背景说明:详见相关文献介绍;传代方法:1:2传代;每周换液2-3次。;生长特性:贴壁生长;形态特性:成纤维细胞;相关产品有:TSCCa细胞、P3X63细胞、GA-10 clone 4细胞
EM-3 Cells;背景说明:髓系白血病;女性;传代方法:1:2-1:3传代;每周换液2-3次。;生长特性:悬浮;形态特性:详见产品说明书;相关产品有:WERI-Rb-1细胞、SUP T1细胞、CNE-2细胞
A-172MG Cells;背景说明:详见相关文献介绍;传代方法:1:2-1:3传代;每周换液2-3次。;生长特性:贴壁或悬浮,详见产品说明书部分;形态特性:详见产品说明书;相关产品有:HLEpiC细胞、SKG IIIa细胞、MD Anderson-Metastatic Breast-361细胞
Hs 274 Cells;背景说明:详见相关文献介绍;传代方法:1:2传代,每周换液2-3次。;生长特性:贴壁生长;形态特性:成纤维细胞;相关产品有:CFPAC-1细胞、TK-10细胞、AML 12细胞
AR42J Cells;背景说明:在肾上腺皮质激素刺激下可诱导出外分泌活性,并伴有广泛的内质网重构。;传代方法:消化3-5分钟。1:2。3天内可长满。;生长特性:贴壁生长;形态特性:上皮样;相关产品有:COR-L88细胞、TI-73细胞、HeLa S 3细胞
SW48 Cells#人结肠腺癌细胞系实验室|完全培养基|鉴定图谱
形态特性:上皮细胞样
DSMZ菌株保藏中心成立于1969年,是德国的国家菌种保藏中心。该中心一直致力于细菌、真菌、质粒、抗菌素、人体和动物细胞、植物病毒等的分类、鉴定和保藏工作。DSMZ菌种保藏中心是欧洲规模最大的生物资源中心,保藏有动物细胞500多株。Riken BRC成立于1920年,是英国的国家菌种保藏中心。该中心一直致力于细菌、真菌、植物病毒等的分类、鉴定和保藏工作。日本Riken BRC(Riken生物资源保藏中心)是全球三大典型培养物收集中心之一。Riken保藏中心提供了很多细胞系。在世界范围内,这些细胞系,都在医学、科学和兽医中具有重要意义。Riken生物资源中心支持了各种学术、健康、食品和兽医机构的研究工作,并在世界各地不同组织的微生物实验室和研究机构中使用。
Abcam HCT 116 IL9 KO Cells(提供STR鉴定图谱)
AG07478 Cells(提供STR鉴定图谱)
BayGenomics ES cell line CSJ040 Cells(提供STR鉴定图谱)
BayGenomics ES cell line SYA285 Cells(提供STR鉴定图谱)
BJ-TERT Cells(提供STR鉴定图谱)
CJUHi001-A Cells(提供STR鉴定图谱)
DA03343 Cells(提供STR鉴定图谱)
ES[MC1R(20):tetFoxj2(6)] Cells(提供STR鉴定图谱)
GM06510 Cells(提供STR鉴定图谱)
SKRC-20 Cells;背景说明:肾癌;传代方法:1:2-1:3传代;每周换液2-3次。;生长特性:贴壁;形态特性:详见产品说明书;相关产品有:NCI-H2342细胞、JOSK-M细胞、SUM 52细胞
E6-1 Cells;背景说明:详见相关文献介绍;传代方法:1:2-1:3传代;每周换液2-3次。;生长特性:贴壁或悬浮,详见产品说明书部分;形态特性:详见产品说明书;相关产品有:FRhK-4细胞、293 c18细胞、143 B细胞
GM346 Cells;背景说明:皮下结缔组织;自发永生;雄性;C3H/An;传代方法:1:2-1:3传代;每周换液2-3次。;生长特性:贴壁;形态特性:详见产品说明书;相关产品有:LN 229细胞、HS-766-T细胞、NCI-H2286细胞
JIMT-1 Cells;背景说明:乳腺癌;女性;传代方法:1:2-1:3传代;每周换液2-3次。;生长特性:贴壁;形态特性:详见产品说明书;相关产品有:TFK1细胞、H-1568细胞、BJA-B细胞
B6Tert-1 Cells;背景说明:滋养层;HGNC-TRET永生;女性;传代方法:1:2-1:3传代;每周换液2-3次。;生长特性:贴壁;形态特性:详见产品说明书;相关产品有:CEM-0细胞、EL4细胞、SNT8细胞
AdHek Cells;背景说明:详见相关文献介绍;传代方法:1:2传代;生长特性:贴壁生长;形态特性:详见产品说明书;相关产品有:BHT101细胞、WPE-int细胞、Hs 766细胞
SW48 Cells#人结肠腺癌细胞系实验室|完全培养基|鉴定图谱
CMT.64 Cells;背景说明:肺腺癌;雌性;C57;传代方法:1:2-1:3传代;每周换液2-3次。;生长特性:贴壁;形态特性:详见产品说明书;相关产品有:Mv.1.Lu细胞、NCI-H2135细胞、Mel-RM细胞
PL9 Cells;背景说明:详见相关文献介绍;传代方法:1:2传代;生长特性:贴壁生长;形态特性:上皮样;相关产品有:Centre Antoine Lacassagne-78细胞、CAKI1细胞、MDA-MB-231-GFP细胞
Oregon J-111 Cells;背景说明:单核细胞白血病;传代方法:1:2-1:3传代;每周换液2-3次。;生长特性:悬浮;形态特性:详见产品说明书;相关产品有:RGC6细胞、hTERT-HME1细胞、ARIP细胞
CAL 120 Cells;背景说明:详见相关文献介绍;传代方法:1:2-1:3传代;每周换液2-3次。;生长特性:贴壁或悬浮,详见产品说明书部分;形态特性:详见产品说明书;相关产品有:CV-1.K细胞、D562细胞、MRC9细胞
293FT Cells;背景说明:该细胞稳定表达SV40大T抗原,并且促进最适病毒产物的产生。;传代方法:1:2传代;生长特性:悬浮生长;形态特性:圆形;相关产品有:Panc327细胞、BC3 H1细胞、C4-2 B细胞
NUGC-4 Cells;背景说明:胃癌;女性;传代方法:1:2-1:3传代;每周换液2-3次。;生长特性:半贴壁;形态特性:详见产品说明书;相关产品有:WSU-DLCL-2细胞、CF-1 MEF细胞、Be-Wo细胞
mRTEC Cells;背景说明:肾小管;上皮 Cells;传代方法:1:2-1:3传代;每周换液2-3次。;生长特性:贴壁;形态特性:详见产品说明书;相关产品有:MOLM-14细胞、MES13细胞、LL2细胞
HOS Cells;背景说明:详见相关文献介绍;传代方法:1:2-1:4传代;每周换液2-3次。;生长特性:贴壁生长;形态特性:成纤维细胞和上皮细胞的混合样;相关产品有:S16细胞、COLO680N细胞、MIA-PaCa-2细胞
BetaTC6 Cells;背景说明:这株细胞来源于转基因小鼠中生长的一个胰肿瘤(胰岛素瘤)。这种小鼠携带了大鼠胰岛素II基因启动子调控的SV40早期基因的假基因结构。细胞包含丰富的胰岛素和小量的胰高血糖素及生长抑素。响应葡萄糖而分泌胰岛素;传代方法:1:2-1:4传代,每2-3天换液一次;生长特性:贴壁生长;形态特性:上皮细胞样;相关产品有:NIH-OVCAR-3细胞、Hs895.T细胞、A-172细胞
BAEC Cells;背景说明:主动脉;内皮 Cells;传代方法:1:2-1:3传代;每周换液2-3次。;生长特性:贴壁;形态特性:详见产品说明书;相关产品有:C28/I2细胞、H295细胞、LK2细胞
BAEC Cells;背景说明:主动脉;内皮 Cells;传代方法:1:2-1:3传代;每周换液2-3次。;生长特性:贴壁;形态特性:详见产品说明书;相关产品有:C28/I2细胞、H295细胞、LK2细胞
H1781 Cells;背景说明:详见相关文献介绍;传代方法:1:2-1:3传代;每周换液2-3次。;生长特性:贴壁或悬浮,详见产品说明书部分;形态特性:详见产品说明书;相关产品有:MAC1细胞、mREC细胞、HEC151细胞
B/C3T3 Cells;背景说明:胚胎;成纤维;自发永生;雄性;BALB/c;传代方法:1:2-1:3传代;每周换液2-3次。;生长特性:贴壁;形态特性:详见产品说明书;相关产品有:NCI-H1672细胞、HMC细胞、HNE3细胞
AML-EOL-1 Cells;背景说明:急性髓系白血病;男性;传代方法:1:2-1:3传代;每周换液2-3次。;生长特性:悬浮;形态特性:详见产品说明书;相关产品有:HSAS1细胞、FAK+/+细胞、NCI-H2009细胞
NCI-H1650 Cells;背景说明:该细胞是从一名27岁白人男性(10年烟龄)支气管肺泡癌患者的胸腔积液中分离得到的。;传代方法:1:4-1:6传代;2-3天换液1次。;生长特性:贴壁生长;形态特性:上皮细胞样;相关产品有:P30/0HK细胞、Normal fibroblast-10细胞、SKRC-42细胞
SLK Cells;背景说明:肉瘤;传代方法:1:2-1:3传代;每周换液2-3次。;生长特性:贴壁;形态特性:详见产品说明书;相关产品有:SUM-52-PE细胞、SK_N_BE2C细胞、CAMA细胞
LC-1 sq Cells;背景说明:详见相关文献介绍;传代方法:1:2-1:3传代;每周换液2-3次。;生长特性:贴壁或悬浮,详见产品说明书部分;形态特性:详见产品说明书;相关产品有:CEM/C1细胞、NCI-H1618细胞、Bac1 2F5细胞
H2452 Cells;背景说明:详见相关文献介绍;传代方法:消化3-5分钟。1:2。3天内可长满。;生长特性:贴壁生长;形态特性:上皮样;相关产品有:BrCL12细胞、PTK2细胞、EB2细胞
HN13 Cells;背景说明:舌鳞癌;女性;传代方法:1:2-1:3传代;每周换液2-3次。;生长特性:贴壁;形态特性:详见产品说明书;相关产品有:16-HBEo细胞、B16 F10细胞、R 1610细胞
Oregon J-111 Cells;背景说明:单核细胞白血病;传代方法:1:2-1:3传代;每周换液2-3次。;生长特性:悬浮;形态特性:详见产品说明书;相关产品有:RGC6细胞、hTERT-HME1细胞、ARIP细胞
VP303 Cells;背景说明:详见相关文献介绍;传代方法:1:2-1:3传代;每周换液2-3次。;生长特性:贴壁或悬浮,详见产品说明书部分;形态特性:详见产品说明书;相关产品有:Huh-7细胞、COLO 205细胞、MOLP-8细胞
SF767 Cells;背景说明:脑瘤;女性;传代方法:1:2-1:3传代;每周换液2-3次。;生长特性:贴壁;形态特性:详见产品说明书;相关产品有:A2780CP70细胞、TE14细胞、KE 37细胞
┈订┈购(技术服务)┈热┈线:1┈3┈6┈4┈1┈9┈3┈0┈7┈9┈1【微信同号】┈Q┈Q:3┈1┈8┈0┈8┈0┈7┈3┈2┈4;
MC26 Cells;背景说明:详见相关文献介绍;传代方法:1:2-1:3传代;每周换液2-3次。;生长特性:贴壁或悬浮,详见产品说明书部分;形态特性:详见产品说明书;相关产品有:Hs-274-T细胞、TW 01细胞、HC-11细胞
DHL-4 Cells;背景说明:详见相关文献介绍;传代方法:1:2-1:3传代;每周换液2-3次。;生长特性:悬浮;形态特性:淋巴母细胞;相关产品有:NTHY-ORI3.1细胞、Panc-813细胞、H2110细胞
293 HEK Cells;背景说明:详见相关文献介绍;传代方法:1:2-1:3传代;每周换液2-3次。;生长特性:贴壁或悬浮,详见产品说明书部分;形态特性:详见产品说明书;相关产品有:FAO-1细胞、Huh 7.5细胞、Sp 2/0-Ag 14细胞
H1993 Cells;背景说明:详见相关文献介绍;传代方法:1:2—1:6传代;生长特性:贴壁或悬浮,详见产品说明书部分;形态特性:详见产品说明书;相关产品有:Calu-1细胞、U20-S细胞、Centre Antoine Lacassagne-39细胞
Pt K2 Cells;背景说明:详见相关文献介绍;传代方法:1:2-1:3传代;每周换液2-3次。;生长特性:贴壁或悬浮,详见产品说明书部分;形态特性:详见产品说明书;相关产品有:Mouse podocyte细胞、MHCC 97-H细胞、KM12细胞
L M (TK-) Cells;背景说明:详见相关文献介绍;传代方法:1:2-1:3传代;每周换液2-3次。;生长特性:贴壁或悬浮,详见产品说明书部分;形态特性:详见产品说明书;相关产品有:UT-7细胞、FRTL-5细胞、58F细胞
H69/P Cells;背景说明:详见相关文献介绍;传代方法:1:2—1:4传代,每周换液2次;生长特性:悬浮生长,聚团;形态特性:聚团悬浮;相关产品有:Mo 59J细胞、SNU-1040细胞、HFT-8810细胞
EBTr (NBL-4) Cells;背景说明:详见相关文献介绍;传代方法:1:2-1:3传代;每周换液2-3次。;生长特性:贴壁或悬浮,详见产品说明书部分;形态特性:详见产品说明书;相关产品有:Hep3B细胞、MD Anderson-Metastatic Breast-134-VI细胞、HHL5细胞
hFOB1.19 Cells;背景说明:成骨细胞;SV40转化;条件永生;女性;传代方法:1:2-1:3传代;每周换液2-3次。;生长特性:贴壁;形态特性:详见产品说明书;相关产品有:Helacyton gartleri细胞、IPLB-SF 21细胞、Ramos细胞
GSC#413 Cells(提供STR鉴定图谱)
HAP1 PPP1R9B (-) 2 Cells(提供STR鉴定图谱)
HG01053 Cells(提供STR鉴定图谱)
HTR.B7-1/IL-12 Cells(提供STR鉴定图谱)
KUM7 Cells(提供STR鉴定图谱)
MRC-iPS-77 Cells(提供STR鉴定图谱)
OC3 Cells(提供STR鉴定图谱)
RLD-1 [Rat] Cells(提供STR鉴定图谱)
SW48 RAC1 (Q61L/+/+) Cells(提供STR鉴定图谱)
Ubigene HeLa PFKFB4 KO Cells(提供STR鉴定图谱)
XP1HEF Cells(提供STR鉴定图谱)
T/GHA-VSMC Cells;背景说明:详见相关文献介绍;传代方法:1:2-1:3传代;每周换液2-3次。;生长特性:贴壁或悬浮,详见产品说明书部分;形态特性:详见产品说明书;相关产品有:SGC-7901细胞、NCIH441细胞、KOSC2细胞
MES-SA/Dx5 Cells;背景说明:详见相关文献介绍;传代方法:1:2-1:8传代;每周2-3次。;生长特性:贴壁生长;形态特性:成纤维细胞样 ;相关产品有:Glioma-261细胞、B16-F1细胞、HANK1细胞
Panc-1-P Cells;背景说明:这株人胰腺癌细胞株源自于胰腺癌导管细胞,其倍增时间为52小时。染色体研究表明,该细胞染色体众数为63,包括3个独特标记的染色体和1个小环状染色体。该细胞的生长可被1unit/ml的左旋天冬酰胺酶抑制;能在软琼脂上生长;能在裸鼠上成瘤。;传代方法:1:2-1:4传代;每周2-3次。;生长特性:贴壁生长;形态特性:上皮样;多角形;相关产品有:NCI-H460细胞、GM03570E细胞、PLA801-95D细胞
H1792 Cells;背景说明:详见相关文献介绍;传代方法:1:3-1:8传代。;生长特性:贴壁生长;形态特性:上皮细胞样;相关产品有:IM9细胞、Caco-2BBe细胞、MRC-V细胞
BE(2)M-17 Cells;背景说明:详见相关文献介绍;传代方法:1:2-1:3传代;每周换液2-3次。;生长特性:贴壁或悬浮,详见产品说明书部分;形态特性:详见产品说明书;相关产品有:P3X63 AG8-653细胞、GM00637B细胞、50.B1细胞
REC Cells;背景说明:详见相关文献介绍;传代方法:1:3—1:6传代,2-3天换液1次;生长特性:悬浮生长 ;形态特性:淋巴母细胞样;相关产品有:JROECL21细胞、SUD6细胞、C4-2B细胞
ARPE-19 Cells;背景说明:详见相关文献介绍;传代方法:1:2传代;生长特性:贴壁生长;形态特性:上皮样;相关产品有:CoCL3细胞、TMK-1细胞、MDA 1386细胞
C-Lu65 Cells;背景说明:详见相关文献介绍;传代方法:1:10传代;生长特性:贴壁生长;形态特性:成纤维细胞;相关产品有:MOLP-2细胞、RCC10细胞、NCIH2009细胞
ANA-1 Cells;背景说明:详见相关文献介绍;传代方法:1:2传代;生长特性:悬浮生长;形态特性:详见产品说明书;相关产品有:RBE4细胞、Rat 2细胞、NCI-460细胞
Ramos 2G6 4C10 Cells;背景说明:详见相关文献介绍;传代方法: 维持细胞浓度在2×105/ml-1×106/ml;根据细胞浓度每2-3天补液1次。;生长特性:悬浮生长 ;形态特性:淋巴母细胞样;相关产品有:PANC-04-03细胞、TE-85细胞、Statens Seruminstitut Rabbit Cornea细胞
HT-29/CX-1 Cells;背景说明:详见相关文献介绍;传代方法:1:2-1:3传代;每周换液2-3次。;生长特性:贴壁或悬浮,详见产品说明书部分;形态特性:详见产品说明书;相关产品有:231-luc细胞、PC-3/M细胞、HL60细胞
HEP-3B2 Cells;背景说明:肝癌;男性;传代方法:1:2-1:3传代;每周换液2-3次。;生长特性:贴壁;形态特性:详见产品说明书;相关产品有:CNE-2Z细胞、OCLY8细胞、KMM-1细胞
CCF-STTG1 Cells;背景说明:详见相关文献介绍;传代方法:1:3—1:6传代;每周换液2-3次;生长特性:贴壁生长;形态特性:星形胶质细胞;相关产品有:MT-2J细胞、ME 180细胞、NCI-H1184细胞
AML-2 Cells;背景说明:急性髓系白血病;男性;传代方法:1:2-1:3传代;每周换液2-3次。;生长特性:悬浮;形态特性:详见产品说明书;相关产品有:OCI-Ly7细胞、NCI-H1755细胞、C-28I2细胞
MNNG/HOS Clone F-5 Cells;背景说明:骨肉瘤;女性;传代方法:1:2-1:3传代;每周换液2-3次。;生长特性:贴壁;形态特性:详见产品说明书;相关产品有:SJSA1细胞、DHL-16细胞、GM02131A细胞
A-431 Cells;背景说明:该细胞源自一位患有皮肤鳞状细胞癌的85岁女性,是GiardDJ等人建立的一系列细胞株中的一株。该细胞在免疫抑制小鼠体内可成瘤,在琼脂上培养可形成克隆;是一个超三倍体人细胞株。;传代方法:1:2传代;生长特性:贴壁生长;形态特性:上皮样;相关产品有:RL95-2细胞、Raji细胞、SKBR-3细胞
A-253 Cells;背景说明:详见相关文献介绍;传代方法:1:2-1:3传代;每周换液2-3次。;生长特性:贴壁或悬浮,详见产品说明书部分;形态特性:详见产品说明书;相关产品有:RPMI2650细胞、GA-10-Clone-4细胞、SW756细胞
C3H/10T1/2 clone 8 Cells;背景说明:详见相关文献介绍;传代方法:1:2-1:3传代;每周换液2-3次。;生长特性:贴壁或悬浮,详见产品说明书部分;形态特性:详见产品说明书;相关产品有:TE 32细胞、PIG1细胞、RPMI-8402细胞
MDA MB 361 Cells;背景说明:该细胞源自40岁女性乳腺癌的脑转移组织。;传代方法: 1:2—1:6传代,每周换液2—3次;生长特性:松散贴壁生长;形态特性:上皮细胞样;相关产品有:H3255_DA细胞、Renal Proximal Tubule Epithelial Cells/TERT-immortalized 1细胞、HFF-1细胞
138 MG Cells;背景说明:星形细胞瘤;男性;传代方法:1:2-1:3传代;每周换液2-3次。;生长特性:贴壁;形态特性:详见产品说明书;相关产品有:HCC-9724细胞、A-204细胞、C2BBe1细胞
HEK293-A Cells;背景说明:胚肾;腺病毒包装;传代方法:1:2-1:3传代;每周换液2-3次。;生长特性:贴壁;形态特性:详见产品说明书;相关产品有:UPCI:SCC154细胞、H-2170细胞、C-4-I细胞
BHP 10-3 Cells;背景说明:甲状腺乳头状癌;女性;传代方法:1:2-1:3传代;每周换液2-3次。;生长特性:贴壁;形态特性:详见产品说明书;相关产品有:W133细胞、Jurkat clone A3细胞、RPMI 1788细胞
TCCSUP Cells;背景说明:详见相关文献介绍;传代方法:1:2-1:3传代,2-3天换液1次。;生长特性:贴壁生长;形态特性:上皮细胞;相关产品有:DiFi细胞、FOX-NY细胞、KYSE-70细胞
WRL68 Cells;背景说明:胚胎;肝 Cells;传代方法:1:2-1:3传代;每周换液2-3次。;生长特性:贴壁;形态特性:详见产品说明书;相关产品有:D-283细胞、H-2107细胞、LC-2/ad细胞
Colo-206F Cells;背景说明:详见相关文献介绍;传代方法:1:2-1:3传代;每周换液2-3次。;生长特性:贴壁或悬浮,详见产品说明书部分;形态特性:详见产品说明书;相关产品有:Shadyside Hospital Pittsburgh-77细胞、V-79细胞、NCI-H1930细胞
GP-293 Cells;背景说明:详见相关文献介绍;传代方法:1:2-1:3传代;每周换液2-3次。;生长特性:贴壁或悬浮,详见产品说明书部分;形态特性:详见产品说明书;相关产品有:Mo7e细胞、HA1800细胞、BE2C细胞
┈订┈购(技术服务)┈热┈线:1┈3┈6┈4┈1┈9┈3┈0┈7┈9┈1【微信同号】┈Q┈Q:3┈1┈8┈0┈8┈0┈7┈3┈2┈4;
NCI-SNU-475 Cells;背景说明:详见相关文献介绍;传代方法:1:2传代;生长特性:贴壁生长;形态特性:上皮样;相关产品有:PANC-02-03细胞、OCI-Ly07细胞、COLO 320F细胞
HepG2/C3A Cells;背景说明:详见相关文献介绍;传代方法:1:3—1:6传代,每周换液2次;生长特性:贴壁生长;形态特性:上皮样;相关产品有:SUM-102PT细胞、Hs839T细胞、Rin-M-5F细胞
SNT-8 Cells;背景说明:NK/T细胞淋巴瘤;女性;传代方法:1:2-1:3传代;每周换液2-3次。;生长特性:悬浮;形态特性:详见产品说明书;相关产品有:Hs 683细胞、C3A细胞、SUM149细胞
SW48 Cells#人结肠腺癌细胞系实验室|完全培养基|鉴定图谱
SK-SH-SY5Y Cells;背景说明:据报道,该细胞的密度可高达1×106cells/cm2,具有中等水平的多巴胺β羟化酶的活性。;传代方法:1:2传代;生长特性:贴壁生长;形态特性:上皮样;相关产品有:Mel-MeWo细胞、EB2细胞、HPB/ALL细胞
BayGenomics ES cell line RRM105 Cells(提供STR鉴定图谱)
BayGenomics ES cell line XN727 Cells(提供STR鉴定图谱)
GT512muMAB 64A Cells(提供STR鉴定图谱)
OX-50 Cells(提供STR鉴定图谱)
4B5 [Mouse/rat hybridoma against mouse Ncl] Cells(提供STR鉴定图谱)
MDA-STn b Cells(提供STR鉴定图谱)
"